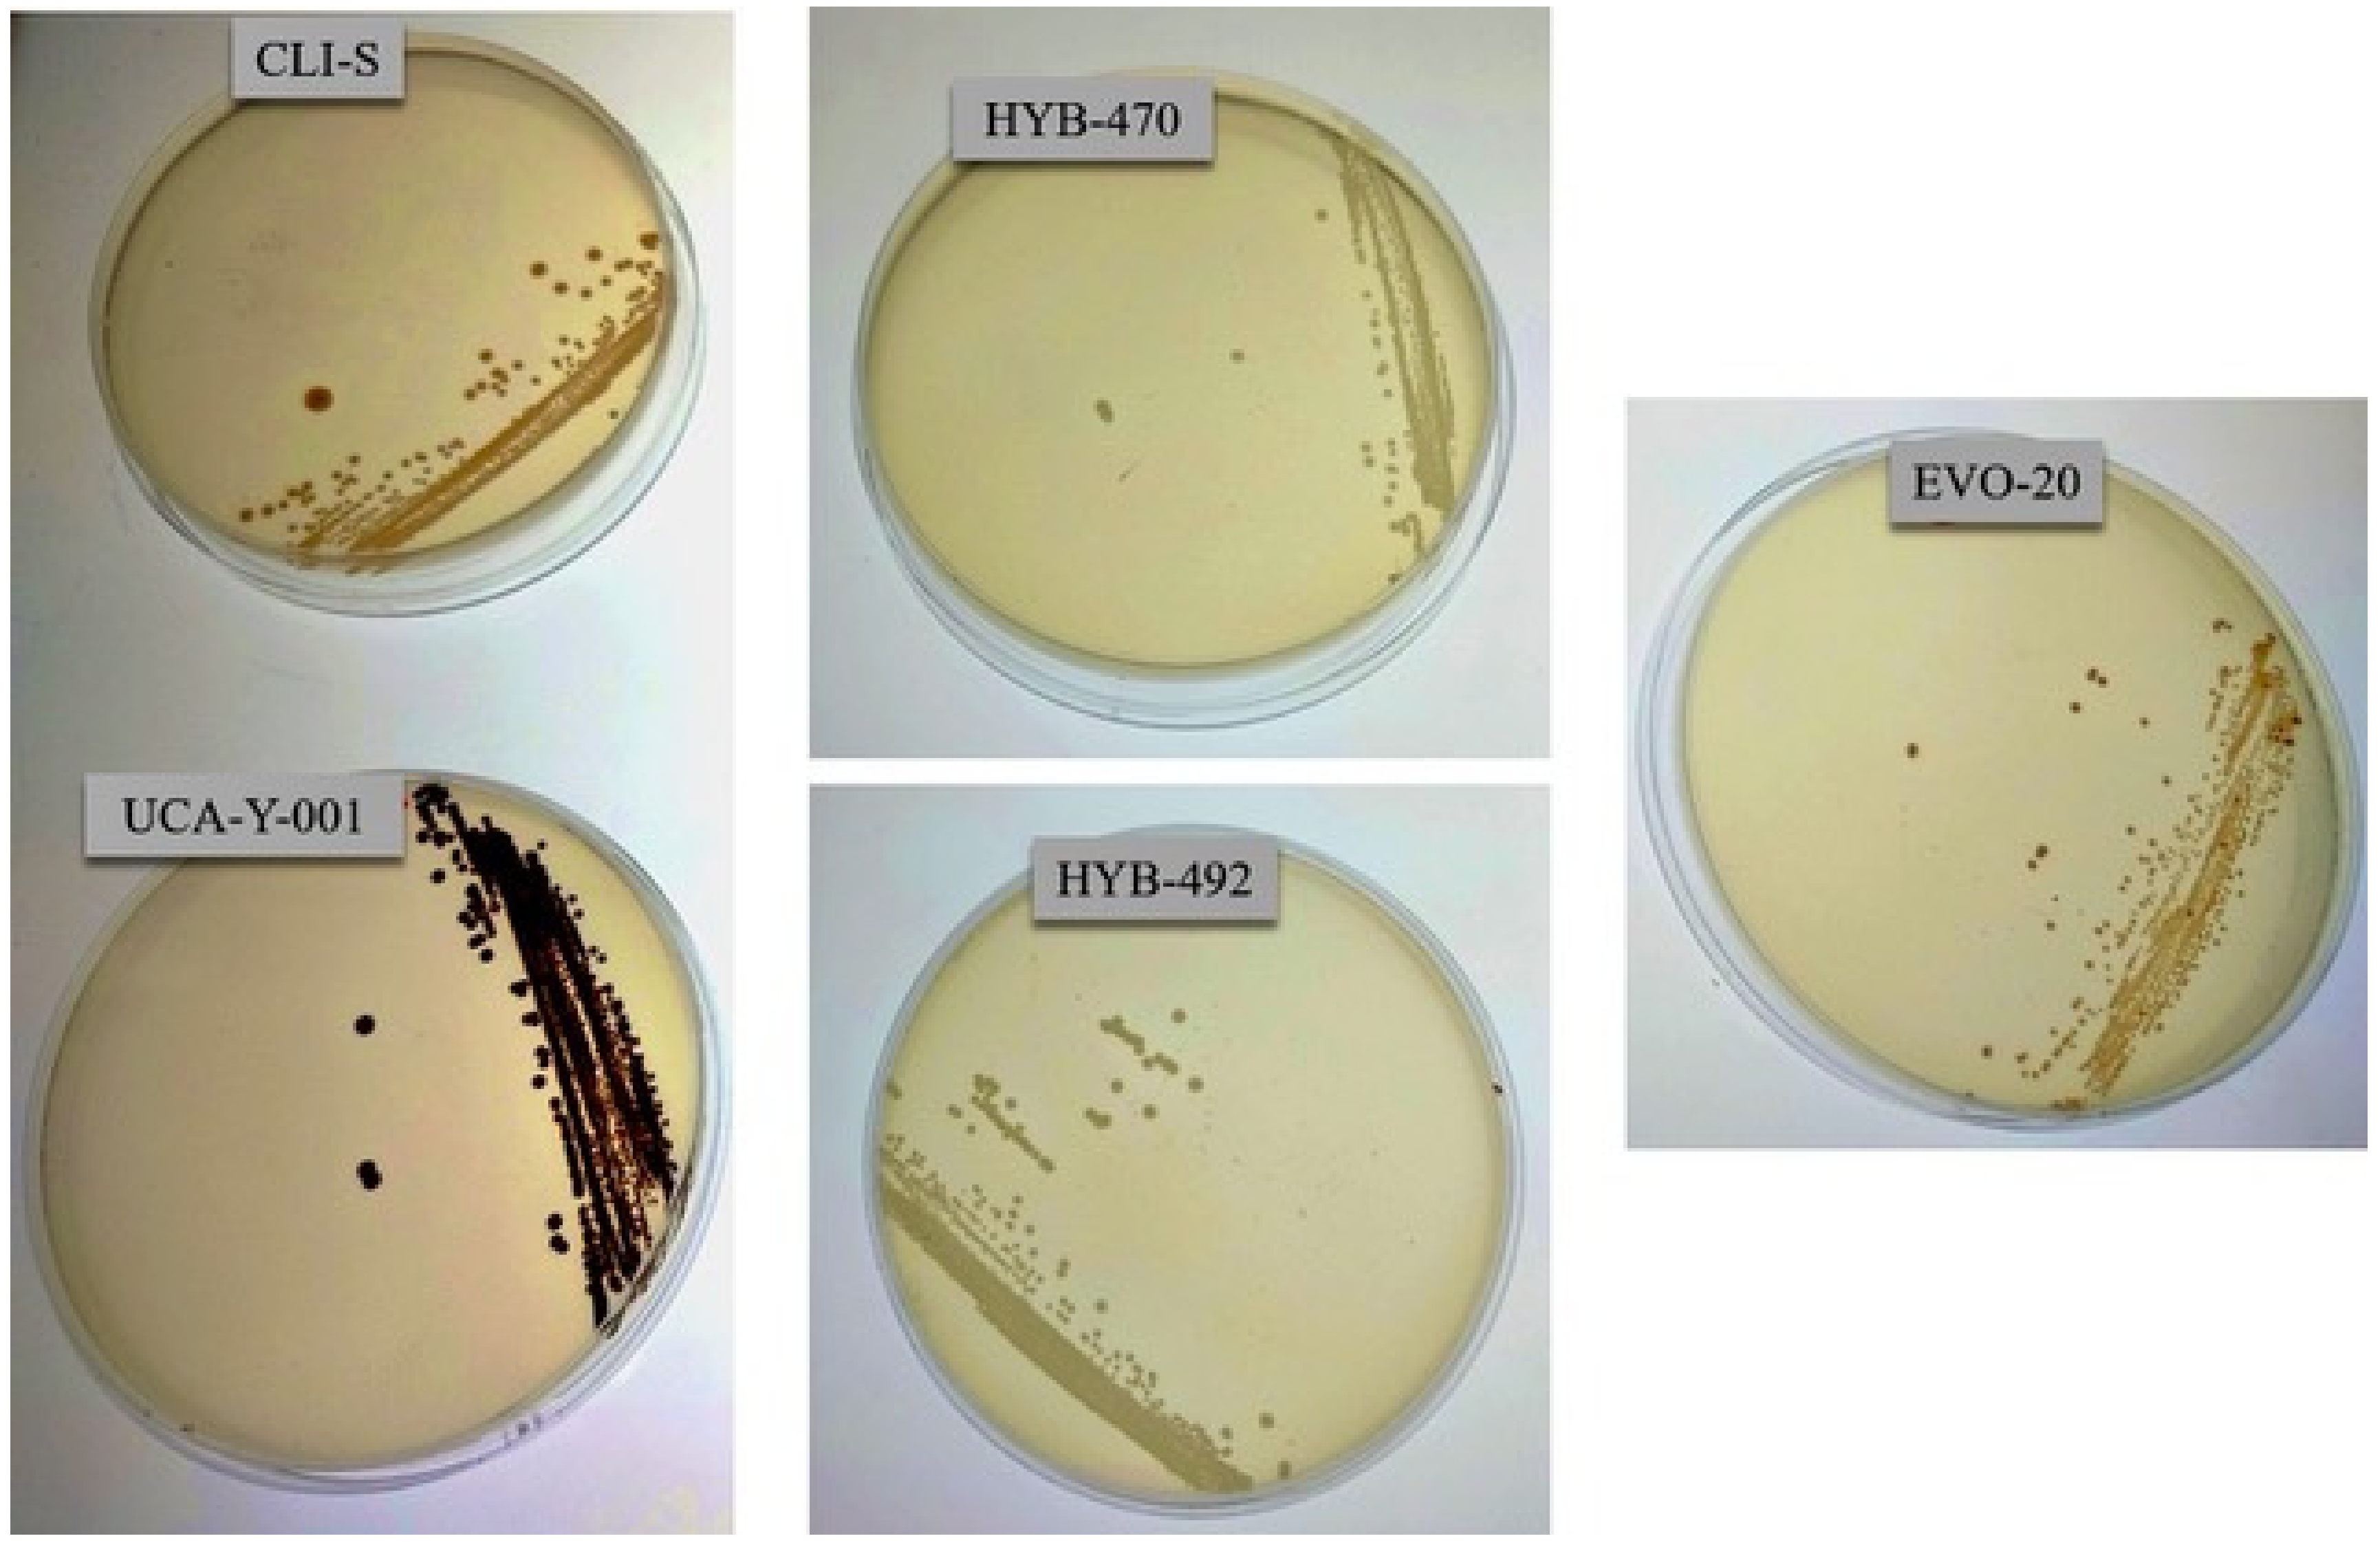

マイストア
変更
お店で受け取る
(送料無料)
配送する
納期目安:
2025.08.26 18:30頃のお届け予定です。
決済方法が、クレジット、代金引換の場合に限ります。その他の決済方法の場合はこちらをご確認ください。
※土・日・祝日の注文の場合や在庫状況によって、商品のお届けにお時間をいただく場合がございます。
Sherry TA.effects s-l400.jpgの詳細情報
s-l400.jpg。Tim Holtz Fossilized Amber Distress Spritz tdu86314 – Simon。Sherry colored topaz。3_3e5fe983-b741-4d32-962b-。⚪️CE PreampBOSS CE-1のプリアンプ部分の回路図を参考に作成実機同様TOSHIBA TA7136APとNEC 2SC900を使用電源入力:9V センターマイナス(電池使用不可)右ジャック:in左ジャック:outノブ:Level左スイッチ:上HIGH 下LOWケースサイズ:1590A同等 約92.5(D)×38.5(W)×31(H)mm配線材:BELDENはんだ:KESTER44⚪️Active Para Boxアクティブパラボックス(アクティブスプリッター)1IN - 2OUT電源:9Vセンターマイナス (電池不可)ケースサイズ:1590A同等 約92.5(D)×38.5(W)×31(H)mm配線材:BELDENはんだ:KESTER44#ギター#エフェクター#TAeffects
ベストセラーランキングです
近くの売り場の商品
カスタマーレビュー
オススメ度 4.8点
現在、2598件のレビューが投稿されています。